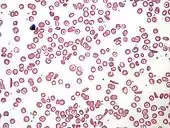

Linus Pauling
Linus Carl Pauling (/ˈpɔːlɪŋ/; February 28, 1901 – August 19, 1994)[4] was an American chemist, biochemist, chemical engineer, peace activist, author, and educator. He published more than 1,200 papers and books, of which about 850 dealt with scientific topics.[5] New Scientist called him one of the 20 greatest scientists of all time,[6] and as of 2000, he was rated the 16th most important scientist in history.[7] For his scientific work, Pauling was awarded the Nobel Prize in Chemistry in 1954. For his peace activism, he was awarded the Nobel Peace Prize in 1962. He is one of four individuals to have won more than one Nobel Prize (the others being Marie Curie, John Bardeen and Frederick Sanger).[8] Of these, he is the only person to have been awarded two unshared Nobel Prizes,[9] and one of two people to be awarded Nobel Prizes in different fields, the other being Marie Curie.[8] He was married to the American human rights activist Ava Helen Pauling.
Pauling was one of the founders of the fields of quantum chemistry and molecular biology.[10] His contributions to the theory of the chemical bond include the concept of orbital hybridisation and the first accurate scale of electronegativities of the elements. Pauling also worked on the structures of biological molecules, and showed the importance of the alpha helix and beta sheet in protein secondary structure. Pauling's approach combined methods and results from X-ray crystallography, molecular model building, and quantum chemistry. His discoveries inspired the work of James Watson, Francis Crick, Maurice Wilkins and Rosalind Franklin on the structure of DNA, which in turn made it possible for geneticists to crack the DNA code of all organisms.[11]
In his later years he promoted nuclear disarmament, as well as orthomolecular medicine, megavitamin therapy,[12] and dietary supplements.
Early life and education

Linus Carl Pauling was born on February 28, 1901, in Portland, Oregon,[13][14] the firstborn child of Herman Henry William Pauling (1876–1910) and Lucy Isabelle "Belle" Darling (1881–1926).[15] He was named "Linus Carl", in honor of Lucy's father, Linus, and Herman's father, Carl.[16] His father was German while his mother was English.
In 1902, after his sister Pauline was born, Pauling's parents decided to move out of Portland, to find more affordable and spacious living quarters than their one-room apartment.[17] Lucy stayed with her husband's parents in Lake Oswego until Herman brought the family to Salem, where he worked briefly as a traveling salesman for the Skidmore Drug Company. Within a year of Lucile's birth in 1904, Herman Pauling moved his family to Lake Oswego, where he opened his own drugstore.[17] He moved his family to Condon, Oregon, in 1905.[18] By 1906, Herman Pauling was suffering from recurrent abdominal pain. He died of a perforated ulcer on June 11, 1910, leaving Lucy to care for Linus, Lucile and Pauline.[19]
Pauling attributes his interest in becoming a chemist to being amazed by experiments conducted by a friend, Lloyd A. Jeffress, who had a small chemistry lab kit.[20] He later wrote: "I was simply entranced by chemical phenomena, by the reactions in which substances, often with strikingly different properties, appear; and I hoped to learn more and more about this aspect of the world."[21]
In high school, Pauling conducted chemistry experiments by scavenging equipment and material from an abandoned steel plant. With an older friend, Lloyd Simon, Pauling set up Palmon Laboratories in Simon's basement. They approached local dairies offering to perform butterfat samplings at cheap prices but dairymen were wary of trusting two boys with the task, and the business ended in failure.[22]
At age 15, the high school senior had enough credits to enter Oregon State University (OSU), known then as Oregon Agricultural College.[23] Lacking two American history courses required for his high school diploma, Pauling asked the school principal if he could take the courses concurrently during the spring semester. Denied, he left Washington High School in June without a diploma.[24] The school awarded him an honorary diploma 45 years later, after he was awarded two Nobel Prizes.[8][25][26]
Pauling held a number of jobs to earn money for his future college expenses, including working part-time at a grocery store for $8 per week (equivalent to $190 in 2019). His mother arranged an interview with the owner of a number of manufacturing plants in Portland, Mr. Schwietzerhoff, who hired him as an apprentice machinist at a salary of $40 per month (equivalent to $940 in 2019). This was soon raised to $50 per month.[27] Pauling also set up a photography laboratory with two friends.[28] In September 1917, Pauling was finally admitted by Oregon State University. He immediately resigned from the machinist's job and informed his mother, who saw no point in a university education, of his plans.[29]
Higher education

In his first semester, Pauling registered for two courses in chemistry, two in mathematics, mechanical drawing, introduction to mining and use of explosives, modern English prose, gymnastics and military drill.[30] He was active in campus life and founded the school's chapter of the Delta Upsilon fraternity.[31] After his second year, he planned to take a job in Portland to help support his mother. The college offered him a position teaching quantitative analysis, a course he had just finished taking himself. He worked forty hours a week in the laboratory and classroom and earned $100 a month (equivalent to $1,300 in 2019), enabling him to continue his studies.[32]
In his last two years at school, Pauling became aware of the work of Gilbert N. Lewis and Irving Langmuir on the electronic structure of atoms and their bonding to form molecules.[32] He decided to focus his research on how the physical and chemical properties of substances are related to the structure of the atoms of which they are composed, becoming one of the founders of the new science of quantum chemistry.
Engineering professor Samuel Graf selected Pauling to be his teaching assistant in a mechanics and materials course.[33][34][35] During the winter of his senior year, Pauling taught a chemistry course for home economics majors. It was in one of these classes that Pauling met his future wife, Ava Helen Miller.[34]:41[36][37][38]
In 1922, Pauling graduated from Oregon State University[13] (known then as Oregon Agricultural College) with a degree in chemical engineering. He went on to graduate school at the California Institute of Technology (Caltech) in Pasadena, California, under the guidance of Roscoe Dickinson and Richard Tolman.[2] His graduate research involved the use of X-ray diffraction to determine the structure of crystals. He published seven papers on the crystal structure of minerals while he was at Caltech. He received his PhD in physical chemistry and mathematical physics,[1] summa cum laude, in 1925.[39]
Career
| External video | |
|---|---|
![]() | |
In 1926, Pauling was awarded a Guggenheim Fellowship to travel to Europe, to study under German physicist Arnold Sommerfeld in Munich, Danish physicist Niels Bohr in Copenhagen and Austrian physicist Erwin Schrödinger in Zürich. All three were experts in the new field of quantum mechanics and other branches of physics.[3] Pauling became interested in how quantum mechanics might be applied in his chosen field of interest, the electronic structure of atoms and molecules. In Zürich, Pauling was also exposed to one of the first quantum mechanical analyses of bonding in the hydrogen molecule, done by Walter Heitler and Fritz London.[40] Pauling devoted the two years of his European trip to this work and decided to make it the focus of his future research. He became one of the first scientists in the field of quantum chemistry and a pioneer in the application of quantum theory to the structure of molecules.[41]
In 1927, Pauling took a new position as an assistant professor at Caltech in theoretical chemistry.[42] He launched his faculty career with a very productive five years, continuing with his X-ray crystal studies and also performing quantum mechanical calculations on atoms and molecules. He published approximately fifty papers in those five years, and created the five rules now known as Pauling's rules.[43][44] By 1929, he was promoted to associate professor, and by 1930, to full professor.[42] In 1931, the American Chemical Society awarded Pauling the Langmuir Prize for the most significant work in pure science by a person 30 years of age or younger.[45] The following year, Pauling published what he regarded as his most important paper, in which he first laid out the concept of hybridization of atomic orbitals and analyzed the tetravalency of the carbon atom.[46]
At Caltech, Pauling struck up a close friendship with theoretical physicist Robert Oppenheimer, who spent part of his research and teaching schedule away from U.C. Berkeley at Caltech every year.[47][48] Pauling was also affiliated to UC Berkeley as Visiting Lecturer in Physics and Chemistry from 1929 to 1934.[49] Oppenheimer even gave Pauling a stunning personal collection of minerals.[50] The two men planned to mount a joint attack on the nature of the chemical bond: apparently Oppenheimer would supply the mathematics and Pauling would interpret the results. Their relationship soured when Oppenheimer tried to pursue Pauling's wife, Ava Helen. When Pauling was at work, Oppenheimer came to their home and blurted out an invitation to Ava Helen to join him on a tryst in Mexico. She flatly refused, and reported the incident to Pauling. He immediately cut off his relationship with Oppenheimer.[47]:152[48]
In the summer of 1930, Pauling made another European trip, during which he learned about gas-phase electron diffraction from Herman Francis Mark. After returning, he built an electron diffraction instrument at Caltech with a student of his, Lawrence Olin Brockway, and used it to study the molecular structure of a large number of chemical substances.[51]
Pauling introduced the concept of electronegativity in 1932.[52] Using the various properties of molecules, such as the energy required to break bonds and the dipole moments of molecules, he established a scale and an associated numerical value for most of the elements – the Pauling Electronegativity Scale – which is useful in predicting the nature of bonds between atoms in molecules.[53]
In 1936, Pauling was promoted to Chairman of the Division of Chemistry and Chemical Engineering at Caltech, and to the position of Director of the Gates and Crellin laboratories of Chemistry. He would hold both positions until 1958.[42] Pauling also spent a year in 1948 at the University of Oxford as George Eastman Visiting Professor and Fellow of Balliol.[54]
Nature of the chemical bond

In the late 1920s, Pauling began publishing papers on the nature of the chemical bond. Between 1937 and 1938, he took a position as George Fischer Baker Non-Resident Lecturer in Chemistry at Cornell University. While at Cornell, he delivered a series of nineteen lectures[55] and completed the bulk of his famous textbook The Nature of the Chemical Bond.[56][57]:Preface It is based primarily on his work in this area that he received the Nobel Prize in Chemistry in 1954 "for his research into the nature of the chemical bond and its application to the elucidation of the structure of complex substances".[8] Pauling's book has been considered "chemistry's most influential book of this century and its effective bible".[58] In the 30 years after its first edition was published in 1939, the book was cited more than 16,000 times. Even today, many modern scientific papers and articles in important journals cite this work, more than seventy years after the first publication.[59]
Part of Pauling's work on the nature of the chemical bond led to his introduction of the concept of orbital hybridization.[60] While it is normal to think of the electrons in an atom as being described by orbitals of types such as s and p, it turns out that in describing the bonding in molecules, it is better to construct functions that partake of some of the properties of each. Thus the one 2s and three 2p orbitals in a carbon atom can be (mathematically) 'mixed' or combined to make four equivalent orbitals (called sp3 hybrid orbitals), which would be the appropriate orbitals to describe carbon compounds such as methane, or the 2s orbital may be combined with two of the 2p orbitals to make three equivalent orbitals (called sp2 hybrid orbitals), with the remaining 2p orbital unhybridized, which would be the appropriate orbitals to describe certain unsaturated carbon compounds such as ethylene.[57]:111–120 Other hybridization schemes are also found in other types of molecules. Another area which he explored was the relationship between ionic bonding, where electrons are transferred between atoms, and covalent bonding, where electrons are shared between atoms on an equal basis. Pauling showed that these were merely extremes, and that for most actual cases of bonding, the quantum-mechanical wave function for a polar molecule AB is a combination of wave functions for covalent and ionic molecules.[44]:66 Here Pauling's electronegativity concept is particularly useful; the electronegativity difference between a pair of atoms will be the surest predictor of the degree of ionicity of the bond.[61]
The third of the topics that Pauling attacked under the overall heading of "the nature of the chemical bond" was the accounting of the structure of aromatic hydrocarbons, particularly the prototype, benzene.[62] The best description of benzene had been made by the German chemist Friedrich Kekulé. He had treated it as a rapid interconversion between two structures, each with alternating single and double bonds, but with the double bonds of one structure in the locations where the single bonds were in the other. Pauling showed that a proper description based on quantum mechanics was an intermediate structure which was a blend of each. The structure was a superposition of structures rather than a rapid interconversion between them. The name "resonance" was later applied to this phenomenon.[63] In a sense, this phenomenon resembles those of hybridization and also polar bonding, both described above, because all three phenomena involve combining more than one electronic structure to achieve an intermediate result.
Ionic crystal structures
In 1929, Pauling published five rules which help to predict and explain crystal structures of ionic compounds.[64][44] These rules concern (1) the ratio of cation radius to anion radius, (2) the electrostatic bond strength, (3) the sharing of polyhedron corners, edges and faces, (4) crystals containing different cations, and (5) the rule of parsimony.
Biological molecules


In the mid-1930s, Pauling, strongly influenced by the biologically oriented funding priorities of the Rockefeller Foundation's Warren Weaver, decided to strike out into new areas of interest.[65] Although Pauling's early interest had focused almost exclusively on inorganic molecular structures, he had occasionally thought about molecules of biological importance, in part because of Caltech's growing strength in biology. Pauling interacted with such great biologists as Thomas Hunt Morgan, Theodosius Dobzhanski, Calvin Bridges and Alfred Sturtevant.[66] His early work in this area included studies of the structure of hemoglobin with his student Charles D. Coryell. He demonstrated that the hemoglobin molecule changes structure when it gains or loses an oxygen atom.[66] As a result of this observation, he decided to conduct a more thorough study of protein structure in general. He returned to his earlier use of X-ray diffraction analysis. But protein structures were far less amenable to this technique than the crystalline minerals of his former work. The best X-ray pictures of proteins in the 1930s had been made by the British crystallographer William Astbury, but when Pauling tried, in 1937, to account for Astbury's observations quantum mechanically, he could not.[67]
It took eleven years for Pauling to explain the problem: his mathematical analysis was correct, but Astbury's pictures were taken in such a way that the protein molecules were tilted from their expected positions. Pauling had formulated a model for the structure of hemoglobin in which atoms were arranged in a helical pattern, and applied this idea to proteins in general.
In 1951, based on the structures of amino acids and peptides and the planar nature of the peptide bond, Pauling, Robert Corey and Herman Branson correctly proposed the alpha helix and beta sheet as the primary structural motifs in protein secondary structure.[68][69] This work exemplified Pauling's ability to think unconventionally; central to the structure was the unorthodox assumption that one turn of the helix may well contain a non-integer number of amino acid residues; for the alpha helix it is 3.7 amino acid residues per turn.
Pauling then proposed that deoxyribonucleic acid (DNA) was a triple helix;[70][71] his model contained several basic mistakes, including a proposal of neutral phosphate groups, an idea that conflicted with the acidity of DNA. Sir Lawrence Bragg had been disappointed that Pauling had won the race to find the alpha helix structure of proteins. Bragg's team had made a fundamental error in making their models of protein by not recognizing the planar nature of the peptide bond. When it was learned at the Cavendish Laboratory that Pauling was working on molecular models of the structure of DNA, James Watson and Francis Crick were allowed to make a molecular model of DNA. They later benefited from unpublished data from Maurice Wilkins and Rosalind Franklin at King's College which showed evidence for a helix and planar base stacking along the helix axis. Early in 1953 Watson and Crick proposed a correct structure for the DNA double helix. Pauling later cited several reasons to explain how he had been misled about the structure of DNA, among them misleading density data and the lack of high quality X-ray diffraction photographs. During the time Pauling was researching the problem, Rosalind Franklin in England was creating the world's best images. They were key to Watson's and Crick's success. Pauling did not see them before devising his mistaken DNA structure, although his assistant Robert Corey did see at least some of them, while taking Pauling's place at a summer 1952 protein conference in England. Pauling had been prevented from attending because his passport was withheld by the State Department on suspicion that he had Communist sympathies. This led to the legend that Pauling missed the structure of DNA because of the politics of the day (this was at the start of the McCarthy period in the United States). Politics did not play a critical role. Not only did Corey see the images at the time, but Pauling himself regained his passport within a few weeks and toured English laboratories well before writing his DNA paper. He had ample opportunity to visit Franklin's lab and see her work, but chose not to.[47]:414–415
Pauling also studied enzyme reactions and was among the first to point out that enzymes bring about reactions by stabilizing the transition state of the reaction, a view which is central to understanding their mechanism of action.[72] He was also among the first scientists to postulate that the binding of antibodies to antigens would be due to a complementarity between their structures.[73] Along the same lines, with the physicist turned biologist Max Delbrück, he wrote an early paper arguing that DNA replication was likely to be due to complementarity, rather than similarity, as suggested by a few researchers. This was made clear in the model of the structure of DNA that Watson and Crick discovered.[74]
Molecular genetics

In November 1949, Pauling, Harvey Itano, S. J. Singer and Ibert Wells published "Sickle Cell Anemia, a Molecular Disease"[75] in the journal Science. It was the first proof of a human disease caused by an abnormal protein, and sickle cell anemia became the first disease understood at the molecular level. Using electrophoresis, they demonstrated that individuals with sickle cell disease have a modified form of hemoglobin in their red blood cells, and that individuals with sickle cell trait have both the normal and abnormal forms of hemoglobin. This was the first demonstration causally linking an abnormal protein to a disease, and also the first demonstration that Mendelian inheritance determines the specific physical properties of proteins, not simply their presence or absence – the dawn of molecular genetics.[76]
His success with sickle cell anemia led Pauling to speculate that a number of other diseases, including mental illnesses such as schizophrenia, might result from flawed genetics. As chairman of the Division of Chemistry and Chemical Engineering and director of the Gates and Crellin Chemical Laboratories, he encouraged the hiring of researchers with a chemical-biomedical approach to mental illness, a direction not always popular with established Caltech chemists.[77]:2
In 1951, Pauling gave a lecture entitled "Molecular Medicine".[78] In the late 1950s, Pauling studied the role of enzymes in brain function, believing that mental illness may be partly caused by enzyme dysfunction.
Structure of the atomic nucleus
On September 16, 1952, Pauling opened a new research notebook with the words "I have decided to attack the problem of the structure of nuclei." On October 15, 1965, Pauling published his Close-Packed Spheron Model of the atomic nucleus in two well respected journals, Science and the Proceedings of the National Academy of Sciences.[79][80] For nearly three decades, until his death in 1994, Pauling published numerous papers on his spheron cluster model.[79][81][82][83][84][85]
The basic idea behind Pauling's spheron model is that a nucleus can be viewed as a set of "clusters of nucleons". The basic nucleon clusters include the deuteron [np], helion [pnp], and triton [npn]. Even–even nuclei are described as being composed of clusters of alpha particles, as has often been done for light nuclei.[86] Pauling attempted to derive the shell structure of nuclei from pure geometrical considerations related to Platonic solids rather than starting from an independent particle model as in the usual shell model. In an interview given in 1990 Pauling commented on his model:[87]
Now recently, I have been trying to determine detailed structures of atomic nuclei by analyzing the ground state and excited state vibrational bends, as observed experimentally. From reading the physics literature, Physical Review Letters and other journals, I know that many physicists are interested in atomic nuclei, but none of them, so far as I have been able to discover, has been attacking the problem in the same way that I attack it. So I just move along at my own speed, making calculations ...
Activism
Wartime work

Pauling had been practically apolitical until World War II. At the beginning of the Manhattan Project, Robert Oppenheimer invited him to be in charge of the Chemistry division of the project. However, he declined, not wanting to uproot his family.[88]


Pauling did, however, work on research for the military. He was a principal investigator on 14 OSRD contracts.[89] The National Defense Research Committee called a meeting on October 3, 1940, wanting an instrument that could reliably measure oxygen content in a mixture of gases, so that they could measure oxygen conditions in submarines and airplanes. In response Pauling designed the Pauling oxygen meter, which was developed and manufactured by Arnold O. Beckman, Inc. After the war, Beckman adapted the oxygen analyzers for use in incubators for premature babies.[90]:180–186[91]
In 1942, Pauling successfully submitted a proposal on "The Chemical Treatment of Protein Solutions in the Attempt to Find a Substitute for Human Serum for Transfusions". His project group, which included J.B. Koepfli and Dan Campbell, developed a possible replacement for human blood plasma in transfusions: polyoxy gelatin (Oxypolygelatin).[92][93]
Other wartime projects with more direct military applications included work on explosives, rocket propellants and the patent for an armor-piercing shell. In October 1948 Pauling was awarded a Presidential Medal for Merit by President Harry S. Truman. The citation credits him for his "imaginative mind", "brilliant success", and "exceptionally meritorious conduct in the performance of outstanding services.[94][95][96] In 1949, he served as president of the American Chemical Society.[97]
Nuclear activism
The aftermath of the Manhattan Project and his wife Ava's pacifism changed Pauling's life profoundly, and he became a peace activist.
In June 1945, a "May-Johnson Bill" began[98][99][100] that would become the Atomic Energy Act of 1946 (signed August 1, 1946). In November 1945, Pauling spoke to the Independent Citizens Committee of the Arts, Sciences and Professions (ICCASP) on atomic weapons; shortly after, wife Ava and he accepted membership.[101] On January 21, 1946, the group met to discuss academic freedom, during which Pauling said, "There is, of course, always a threat to academic freedom – as there is to the other aspects of the freedom and rights of the individual, in the continued attacks which are made on this freedom, these rights, by the selfish, the overly ambitious, the misguided, the unscrupulous, who seek to oppress the great body of mankind in order that they themselves may profit – and we must always be on the alert against this threat, and must fight it with vigor when it becomes dangerous."[101]
In 1946, he joined the Emergency Committee of Atomic Scientists, chaired by Albert Einstein.[102] Its mission was to warn the public of the dangers associated with the development of nuclear weapons.
His political activism prompted the US State Department to deny him a passport in 1952, when he was invited to speak at a scientific conference in London.[103][104] In a speech before the US Senate on June 6 of the same year, Senator Wayne Morse publicly denounced the action of the State Department, and urged the Passport Division to reverse its decision. Pauling and his wife Ava were then issued a "limited passport" to attend the aforementioned conference in England.[105][106] His full passport was restored in 1954, shortly before the ceremony in Stockholm where he received his first Nobel Prize.
Joining Einstein, Bertrand Russell and eight other leading scientists and intellectuals, he signed the Russell-Einstein Manifesto issued July 9, 1955.[107] He also supported the Mainau Declaration of July 15, 1955, signed by 52 Nobel Prize laureates.[108]
In May 1957, working with Washington University in St. Louis professor Barry Commoner, Pauling began to circulate a petition among scientists to stop nuclear testing.[109] On January 15, 1958, Pauling and his wife presented a petition to United Nations Secretary General Dag Hammarskjöld calling for an end to the testing of nuclear weapons. It was signed by 11,021 scientists representing fifty countries.[110][111]
In February 1958, Pauling participated in a publicly televised debate with the atomic physicist Edward Teller about the actual probability of fallout causing mutations.[112] Later in 1958, Pauling published No more war!, in which he not only called for an end to the testing of nuclear weapons but also an end to war itself . He proposed that a World Peace Research Organization be set up as part of the United Nations to "attack the problem of preserving the peace".[8]
Pauling also supported the work of the St. Louis Citizen's Committee for Nuclear Information (CNI).[109] This group, headed by Barry Commoner, Eric Reiss, M. W. Friedlander and John Fowler, organized a longitudinal study to measure radioactive strontium-90 in the baby teeth of children across North America. The "Baby Tooth Survey," published by Dr. Louise Reiss, demonstrated conclusively in 1961 that above-ground nuclear testing posed significant public health risks in the form of radioactive fallout spread primarily via milk from cows that had ingested contaminated grass.[113][114][115] The Committee for Nuclear Information is frequently credited for its significant contribution to supporting the test ban,[116] as is the ground-breaking research conducted by Dr. Reiss and the "Baby Tooth Survey".[117]
Public pressure and the frightening results of the CNI research subsequently led to a moratorium on above-ground nuclear weapons testing, followed by the Partial Test Ban Treaty, signed in 1963 by John F. Kennedy and Nikita Khrushchev. On the day that the treaty went into force, October 10, 1963, the Nobel Prize Committee awarded Pauling the Nobel Peace Prize for 1962. (No prize had previously been awarded for that year.)[118] They described him as "Linus Carl Pauling, who ever since 1946 has campaigned ceaselessly, not only against nuclear weapons tests, not only against the spread of these armaments, not only against their very use, but against all warfare as a means of solving international conflicts."[119] Pauling himself acknowledged his wife Ava's deep involvement in peace work, and regretted that she was not awarded the Nobel Peace Prize with him.[120]
Political criticism
.jpg.webp)
Many of Pauling's critics, including scientists who appreciated the contributions that he had made in chemistry, disagreed with his political positions and saw him as a naïve spokesman for Soviet communism. In 1960, he was ordered to appear before the Senate Internal Security Subcommittee,[121] which termed him "the number one scientific name in virtually every major activity of the Communist peace offensive in this country."[122] A headline in Life magazine characterized his 1962 Nobel Prize as "A Weird Insult from Norway".[123][124]
Pauling was a frequent target of the National Review magazine. In an article entitled "The Collaborators" in the magazine's July 17, 1962 issue, Pauling was referred to not only as a collaborator, but as a "fellow traveler" of proponents of Soviet-style communism. In 1965, Pauling sued the magazine, its publisher William Rusher, and its editor William F. Buckley, Jr for $1 million. He lost both his libel suits and the 1968 appeal.[125][126][127][128]
His peace activism, his frequent travels, and his enthusiastic expansion into chemical-biomedical research all aroused opposition at Caltech. In 1958, the Caltech Board of Trustees demanded that Pauling step down as chairman of the Chemistry and Chemical Engineering Division.[77]:2 Although he had retained tenure as a full professor, Pauling chose to resign from Caltech after he received the Nobel peace prize money. He spent the next three years at the Center for the Study of Democratic Institutions (1963–1967).[21] In 1967, he moved to the University of California at San Diego, but remained there only briefly, leaving in 1969 in part because of political tensions with the Reagan-era board of regents.[77]:3 From 1969 to 1974, he accepted a position as Professor of Chemistry at Stanford University.[42]
Vietnam war activism
During the 1960s, President Lyndon Johnson's policy of increasing America's involvement in the Vietnam War caused an anti-war movement that the Paulings joined with enthusiasm. Pauling denounced the war as unnecessary and unconstitutional. He made speeches, signed protest letters and communicated personally with the North Vietnamese leader, Ho Chi Minh, and gave the lengthy written response to President Johnson. His efforts were ignored by the American government.[129]
Pauling was awarded the International Lenin Peace Prize by the USSR in 1970.[122][130] He continued his peace activism in the following years. He and his wife Ava helped to found the International League of Humanists in 1974.[131] He was president of the scientific advisory board of the World Union for Protection of Life and also one of the signatories of the Dubrovnik-Philadelphia Statement of 1974/1976.[132] Linus Carl Pauling was an honorary president and member of the International Academy of Science, Munich until the end of his life.[133]
Eugenics
Pauling supported a limited form of eugenics by suggesting that human carriers of defective genes be given a compulsory visible mark – such as a forehead tattoo – to discourage potential mates with the same defect, in order to reduce the number of babies with diseases such as sickle cell anemia.[134][135]
Medical research and vitamin C advocacy
In 1941, at age 40, Pauling was diagnosed with Bright's disease, a renal disease. Following the recommendations of Thomas Addis, who actively recruited Ava Helen Pauling as "nutritionist, cook, and eventually as deputy 'doctor'", Pauling believed he was able to control the disease with Addis's then-unusual low-protein salt-free diet and vitamin supplements.[137] Thus Pauling's initial – and intensely personal – exposure to the idea of treating disease with vitamin supplements was positive.
In 1965, Pauling read Niacin Therapy in Psychiatry by Abram Hoffer and theorized vitamins might have important biochemical effects unrelated to their prevention of associated deficiency diseases.[138] In 1968, Pauling published a brief paper in Science entitled "Orthomolecular psychiatry",[139] giving a name to the popular but controversial megavitamin therapy movement of the 1970s, and advocating that "orthomolecular therapy, the provision for the individual person of the optimum concentrations of important normal constituents of the brain, may be the preferred treatment for many mentally ill patients." Pauling coined the term "orthomolecular" to refer to the practice of varying the concentration of substances normally present in the body to prevent and treat disease. His ideas formed the basis of orthomolecular medicine, which is not generally practiced by conventional medical professionals and has been strongly criticized.[140][141]
In 1973, with Arthur B. Robinson and another colleague, Pauling founded the Institute of Orthomolecular Medicine in Menlo Park, California, which was soon renamed the Linus Pauling Institute of Science and Medicine. Pauling directed research on vitamin C, but also continued his theoretical work in chemistry and physics until his death. In his last years, he became especially interested in the possible role of vitamin C in preventing atherosclerosis and published three case reports on the use of lysine and vitamin C to relieve angina pectoris. During the 1990s, Pauling put forward a comprehensive plan for the treatment of heart disease using lysine and vitamin C. In 1996, a website was created expounding Pauling's treatment which it referred to as Pauling Therapy. Proponents of Pauling Therapy believe that heart disease can be treated and even cured using only lysine and Vitamin C and without drugs or heart operations.[142]
Pauling's work on vitamin C in his later years generated much controversy. He was first introduced to the concept of high-dose vitamin C by biochemist Irwin Stone in 1966. After becoming convinced of its worth, Pauling took 3 grams of vitamin C every day to prevent colds.[13] Excited by his own perceived results, he researched the clinical literature and published Vitamin C and the Common Cold in 1970. He began a long clinical collaboration with the British cancer surgeon Ewan Cameron in 1971 on the use of intravenous and oral vitamin C as cancer therapy for terminal patients.[143] Cameron and Pauling wrote many technical papers and a popular book, Cancer and Vitamin C, that discussed their observations. Pauling made vitamin C popular with the public[144] and eventually published two studies of a group of 100 allegedly terminal patients that claimed vitamin C increased survival by as much as four times compared to untreated patients.[145][146]
A re-evaluation of the claims in 1982 found that the patient groups were not actually comparable, with the vitamin C group being less sick on entry to the study, and judged to be "terminal" much earlier than the comparison group.[147] Later clinical trials conducted by the Mayo Clinic also concluded that high-dose (10,000 mg) vitamin C was no better than placebo at treating cancer and that there was no benefit to high-dose vitamin C.[148][149][150] The failure of the clinical trials to demonstrate any benefit resulted in the conclusion that vitamin C was not effective in treating cancer; the medical establishment concluded that his claims that vitamin C could prevent colds or treat cancer were quackery.[13][151] Pauling denounced the conclusions of these studies and handling of the final study as "fraud and deliberate misrepresentation",[152][153] and criticized the studies for using oral, rather than intravenous vitamin C[154] (which was the dosing method used for the first ten days of Pauling's original study[151]). Pauling also criticised the Mayo clinic studies because the controls were taking vitamin C during the trial, and because the duration of the treatment with vitamin C was short; Pauling advocated continued high-dose vitamin C for the rest of the cancer patient's life whereas the Mayo clinic patients in the second trial were treated with vitamin C for a median of 2.5 months.[155] The results were publicly debated at length with considerable acrimony between Pauling and Cameron, and Moertel (the lead author of the Mayo Clinic studies), with accusations of misconduct and scientific incompetence on both sides.
Ultimately the negative findings of the Mayo Clinic studies ended general interest in vitamin C as a treatment for cancer.[153] Despite this, Pauling continued to promote vitamin C for treating cancer and the common cold, working with The Institutes for the Achievement of Human Potential to use vitamin C in the treatment of brain-injured children.[156] He later collaborated with the Canadian physician Abram Hoffer on a micronutrient regime, including high-dose vitamin C, as adjunctive cancer therapy.[157] A 2009 review also noted differences between the studies, such as the Mayo clinic not using intravenous Vitamin C, and suggested further studies into the role of vitamin C when given intravenously.[158]
Personal life

Pauling married Ava Helen Miller on June 17, 1923. The marriage lasted until Ava Pauling's death in 1981. They had four children.[159] Linus Carl Jr. (born 1925) became a psychiatrist; Peter (1931–2003) a crystallographer at University College London; Edward Crellin (1937–1997) a biologist; and Linda Helen (born 1932) married noted Caltech geologist and glaciologist Barclay Kamb.[160]
Pauling was raised as a member of the Lutheran Church,[161] but later joined the Unitarian Universalist Church.[162] Two years before his death, in a published dialogue with Buddhist philosopher Daisaku Ikeda, Pauling publicly declared his atheism.[163]
On January 30, 1960, Pauling and his wife were using a cabin about 80 miles (130 km) south of Monterey, California, and he decided to go for a walk on a coastal trail. He got lost and tried to climb the rocky cliff, but reached a large overhanging rock about 300 feet (90 m) above the ocean. He decided it was safest to stay there, and meanwhile he was reported missing. He spent a sleepless night on the cliff before being found after almost 24 hours.[164]
Death and legacy
Pauling died of prostate cancer on August 19, 1994, at 19:20 at home in Big Sur, California.[165] He was 93 years old.[166] A grave marker for Pauling was placed in Oswego Pioneer Cemetery in Lake Oswego, Oregon by his sister Pauline, but Pauling's ashes, along with those of his wife, were not buried there until 2005.[167]
Pauling's discoveries led to decisive contributions in a diverse array of areas including around 350 publications in the fields of quantum mechanics, inorganic chemistry, organic chemistry, protein structure, molecular biology, and medicine.[168][169]
His work on chemical bonding marks him as one of the founders of modern quantum chemistry.[10] The Nature of the Chemical Bond was the standard work for many years,[170] and concepts like hybridization and electronegativity remain part of standard chemistry textbooks. While his Valence bond approach fell short of accounting quantitatively for some of the characteristics of molecules, such as the color of organometallic complexes, and would later be eclipsed by the molecular orbital theory of Robert Mulliken, Valence Bond Theory still competes, in its modern form, with Molecular Orbital Theory and density functional theory (DFT) as a way of describing the chemical phenomena.[171] Pauling's work on crystal structure contributed significantly to the prediction and elucidation of the structures of complex minerals and compounds.[34]:80–81 His discovery of the alpha helix and beta sheet is a fundamental foundation for the study of protein structure.[69]
Francis Crick acknowledged Pauling as the "father of molecular biology".[10][172] His discovery of sickle cell anemia as a "molecular disease" opened the way toward examining genetically acquired mutations at a molecular level.[76]
Pauling's 1951 publication with Robert B. Corey and H. R. Branson, "The Structure of Proteins: Two Hydrogen-Bonded Helical Configurations of the Polypeptide Chain," was a key early finding in the then newly emerging field of molecular biology. This publication was honored by a Citation for Chemical Breakthrough Award from the Division of History of Chemistry of the American Chemical Society presented to the Department of Chemistry, Caltech, in 2017.[173][174]
Commemorations
Oregon State University completed construction of the $77 million, 100,000-square-foot (9,300 m2) Linus Pauling Science Center in the late 2000s, now housing a bulk of Oregon State's chemistry classrooms, labs, and instruments.[175]
On March 6, 2008, the United States Postal Service released a 41 cent stamp honoring Pauling designed by artist Victor Stabin.[176][177] His description reads: "A remarkably versatile scientist, structural chemist Linus Pauling (1901–1994) won the 1954 Nobel Prize in Chemistry for determining the nature of the chemical bond linking atoms into molecules. His work in establishing the field of molecular biology; his studies of hemoglobin led to the classification of sickle cell anemia as a molecular disease."[76] The other scientists on this sheet of stamps included Gerty Cori, biochemist, Edwin Hubble, astronomer, and John Bardeen, physicist.[177]
California Governor Arnold Schwarzenegger and First Lady Maria Shriver announced on May 28, 2008 that Pauling would be inducted into the California Hall of Fame, located at The California Museum for History, Women and the Arts. The induction ceremony took place December 15, 2008. Pauling's son was asked to accept the honor in his place.[178]
By proclamation of Gov. John Kitzhaber in the state of Oregon, February 28 has been named "Linus Pauling Day".[179] The Linus Pauling Institute still exists, but moved in 1996 from Palo Alto, California, to Corvallis, Oregon, where it is part of the Linus Pauling Science Center at Oregon State University.[180][181][182] The Valley Library Special Collections at Oregon State University contain the Ava Helen and Linus Pauling Papers, including digitized versions of Pauling's forty-six research notebooks.[179]
In 1986, Caltech commemorated Linus Pauling with a Symposium and Lectureship.[183] The Pauling Lecture series at Caltech began in 1989 with a lecture by Pauling himself. The Caltech Chemistry Department renamed room 22 of Gates Hall the Linus Pauling Lecture Hall, since Linus spent so much time there.[184]
Other places named after Pauling include Pauling Street in Foothill Ranch, California;[185] Linus Pauling Drive in Hercules, California; Linus and Ava Helen Pauling Hall at Soka University of America in Aliso Viejo, California;[186] Linus Pauling Middle School in Corvallis, Oregon;[187] and Pauling Field, a small airfield located in Condon, Oregon, where Pauling spent his youth.[188] There is a psychedelic rock band in Houston, Texas, named The Linus Pauling Quartet.[189]
The asteroid 4674 Pauling in the inner asteroid belt, discovered by Eleanor F. Helin, was named after Linus Pauling in 1991, on his 90th birthday.[190]
Linus Torvalds, developer of the Linux kernel, is named after Pauling.[191]
Nobel laureate Peter Agre has said that Linus Pauling inspired him.[192]
In 2010, Pacific Northwest National Laboratory named its distinguished postdoctoral program in his honor, as the Linus Pauling Distinguished Postdoctoral Fellowship Program.
See also
Honors and awards
Pauling received numerous awards and honors during his career, including the following:[193][42][194]
- 1931 ACS Award in Pure Chemistry [195]
- 1931 Irving Langmuir Award, American Chemical Society.[42][194]
- 1940 Alpha Chi Sigma, professional chemistry fraternity.[196]
- 1941 Nichols Medal, New York Section, American Chemical Society.[42]
- 1946 Willard Gibbs Award, Chicago section of the American Chemical Society.[194]
- 1947 Davy Medal, Royal Society.[42][194]
- 1947 T. W. Richards Medal, Northeastern Section of the American Chemical Society.[194]
- 1948 Presidential Medal for Merit by President Harry S. Truman of the United States.[42][194]
- 1948 Elected a Foreign Member of the Royal Society of London (ForMemRS)[13]
- 1951 Gilbert N. Lewis medal, California section of the American Chemical Society.[194]
- 1952 Pasteur Medal, Biochemical Society of France.[42]
- 1954 Nobel Prize in Chemistry.[42][194]
- 1955 Addis Medal, National Nephrosis Foundation.[42][194]
- 1955 John Phillips Memorial Award, American College of Physicians.[42][194]
- 1956 Avogadro Medal, Italian Academy of Science.[42][194]
- 1957 Paul Sabatier Medal.
- 1957 Pierre Fermat Medal in Mathematics (awarded for only the sixth time in three centuries).[42][194][197]
- 1957 International Grotius Medal.[42]
- 1959 Messenger Lectureship
- 1960 Fellow, Royal Society of Arts
- 1961 Humanist of the Year, American Humanist Association.
- 1961 Gandhi Peace Award by Promoting Enduring Peace.[198]
- 1962 Nobel Peace Prize.[42][194]
- 1965 Medal, Academy of the Rumanian People's Republic.[42]
- 1966 Linus Pauling Award.[42]
- 1966 Silver Medal, Institute of France.[42]
- 1966 Supreme Peace Sponsor, World Fellowship of Religion.[42]
- 1967 Washington A. Roebling Medal, Mineralogical Society of America.[194]
- 1972 Lenin Peace Prize.[42]
- 1974 National Medal of Science by President Gerald R. Ford of the United States.[194]
- 1978 Lomonosov Gold Medal, Presidium of the Academy of the USSR.[42][194]
- 1979 Gold Medal Honoree, National Institute of Social Sciences.[199]
- 1979 NAS Award in Chemical Sciences, National Academy of Sciences.[42][200]
- 1979 Golden Plate Award, American Academy of Achievement [201]
- 1981 John K. Lattimer Award, American Urological Association.[194]
- 1984 Priestley Medal, American Chemical Society.[42][194]
- 1984 Award for Chemistry, Arthur M. Sackler Foundation.[42]
- 1986 Lavoisier Medal by Fondation de la Maison de la Chimie.[194]
- 1987 Award in Chemical Education, American Chemical Society.[42]
- 1989 Vannevar Bush Award, National Science Board.[42][194]
- 1990 Richard C. Tolman Medal, American Chemical Society Southern California Section.[42]
- 1992 Daisaku Ikeda Medal, Soka Gakkai International[194]
- 2008 "American Scientists" U.S. postage stamp series, $0.41, for his sickle cell disease work.[202]
Publications
Books
| Library resources about Linus Pauling |
| By Linus Pauling |
|---|
- ——; Wilson, E. B. (1985) [Originally published in 1935]. Introduction to Quantum Mechanics with Applications to Chemistry. Reprinted by Dover Publications. ISBN 978-0-486-64871-2.
- —— (1939). The Nature of the Chemical Bond and the Structure of Molecules and Crystals. Cornell University Press.
- —— (1947). General Chemistry: An Introduction to Descriptive Chemistry and Modern Chemical Theory. W. H. Freeman.
- Greatly revised and expanded in 1947, 1953, and 1970. Reprinted by Dover Publications in 1988.
- ——; Hayward, Roger (1964). The Architecture of Molecules. Proceedings of the National Academy of Sciences of the United States of America. 51. San Francisco: Freeman. pp. 977–84. doi:10.1073/pnas.51.5.977. ISBN 978-0716701583. PMC 300194. PMID 16591181.
- —— (1958). No more war!. Dodd, Mead & Co. ISBN 978-1124119663.
- —— (1977). Vitamin C, the Common Cold and the Flu. W.H. Freeman. ISBN 978-0-7167-0360-0.
- —— (1987). How to Live Longer and Feel Better. Avon. ISBN 978-0-380-70289-3.
- Cameron, E.; —— (1993). Cancer and Vitamin C: A Discussion of the Nature, Causes, Prevention, and Treatment of Cancer With Special Reference to the Value of Vitamin C. Camino. ISBN 978-0-940159-21-1.
- —— (1998). Linus Pauling On Peace: A Scientist Speaks Out on Humanism and World Survival. Rising Star Press. ISBN 978-0-933670-03-7.
- Hoffer, Abram; —— (2004). Healing Cancer: Complementary Vitamin & Drug Treatments. Toronto: CCNM Press. ISBN 978-1897025116.
- Ikeda, Daisaku; —— (2008). A Lifelong Quest for Peace: A Dialogue. Richard L. Gage (ed., trans.). London: I. B. Tauris. ISBN 978-1-84511-889-1.
Journal articles
- —— (1927). "The Theoretical Prediction of the Physical Properties of Many-Electron Atoms and Ions. Mole Refraction, Diamagnetic Susceptibility, and Extension in Space". Proceedings of the Royal Society A: Mathematical, Physical and Engineering Sciences. 114 (767): 181–211. Bibcode:1927RSPSA.114..181P. doi:10.1098/rspa.1927.0035.
- —— (1929). "The Principles Determining the Structure of Complex Ionic Crystals". Journal of the American Chemical Society. 51 (4): 1010–1026. doi:10.1021/ja01379a006.
- —— (1931). "The Nature of the Chemical Bond. I. Application of Results Obtained from the Quantum Mechanics and from a Theory of Paramagnetic Susceptibility to the Structure of Molecules". Journal of the American Chemical Society. 53 (4): 1367–1400. doi:10.1021/ja01355a027.
- —— (1931). "The Nature of the Chemical Bond. II. The One-Electron Bond and the Three-Electron Bond". Journal of the American Chemical Society. 53 (9): 3225–3237. doi:10.1021/ja01360a004.
- —— (1932). "The Nature of the Chemical Bond. III. The Transition from One Extreme Bond Type to Another". Journal of the American Chemical Society. 54 (3): 988–1003. doi:10.1021/ja01342a022.
- —— (1932). "The Nature of the Chemical Bond. IV. The Energy of Single Bonds and the Relative Electronegativity of Atoms". Journal of the American Chemical Society. 54 (9): 3570–3582. doi:10.1021/ja01348a011.
- ——; Wheland, G. W. (1933). "The Nature of the Chemical Bond. V. The Quantum-Mechanical Calculation of the Resonance Energy of Benzene and Naphthalene and the Hydrocarbon Free Radicals" (PDF). The Journal of Chemical Physics. 1 (6): 362. Bibcode:1933JChPh...1..362P. doi:10.1063/1.1749304.
- —— (1935). "The Structure and Entropy of Ice and of Other Crystals with Some Randomness of Atomic Arrangement". Journal of the American Chemical Society. 57 (12): 2680–2684. doi:10.1021/ja01315a102.
- —— (1940). "A Theory of the Structure and Process of Formation of Antibodies*". Journal of the American Chemical Society. 62 (10): 2643–2657. doi:10.1021/ja01867a018.
- —— (1947). "Atomic Radii and Interatomic Distances in Metals". Journal of the American Chemical Society. 69 (3): 542–553. doi:10.1021/ja01195a024.
- ——; Itano, H. A.; Singer, S. J.; Wells, I. C. (1949). "Sickle Cell Anemia, a Molecular Disease". Science. 110 (2865): 543–548. Bibcode:1949Sci...110..543P. doi:10.1126/science.110.2865.543. PMID 15395398.
- ——; Corey, R. B.; Branson, H. R. (1951). "The structure of proteins: Two hydrogen-bonded helical configurations of the polypeptide chain". Proceedings of the National Academy of Sciences. 37 (4): 205–11. Bibcode:1951PNAS...37..205P. doi:10.1073/pnas.37.4.205. PMC 1063337. PMID 14816373.
See also
References
- Pauling, Linus (1925). The determination with x-rays of the structures of crystals (PhD thesis). California Institute of Technology.
- Linus Pauling at the Mathematics Genealogy Project
- "A Guggenheim Fellow in Europe during the Golden Years of Physics (1926–1927)". Special Collections & Archives Research Center. Oregon State University Libraries. Retrieved May 27, 2015.
- https://www.nobelprize.org/prizes/chemistry/1954/pauling/facts/
- Pauling, Linus (1997). Pauling, Jr., Linus (ed.). Selected papers of Linus Pauling (Volume I ed.). River Edge, NJ: World Scientific. p. xvii. ISBN 978-9810229399.
- Horgan, J (1993). "Profile: Linus C. Pauling – Stubbornly Ahead of His Time". Scientific American. 266 (3): 36–40. Bibcode:1993SciAm.266c..36H. doi:10.1038/scientificamerican0393-36.
- Simmons, John (1996). The scientific 100 : a ranking of the most influential scientists, past and present. Secaucus, NY: Carol Publ. Group. ISBN 978-0806517490. Retrieved May 26, 2015.
- Linus Pauling on Nobelprize.org
, accessed 30 April 2020 - "Nobel Prize Facts". Nobelprize.org. Nobel Media AB. 2014. Retrieved January 14, 2017.
- Rich, A. (1994). "Linus Pauling (1901–1994)". Nature. 371 (6495): 285. Bibcode:1994Natur.371..285R. doi:10.1038/371285a0. PMID 8090196. S2CID 8923975.
- Gribbin, J (2002). The Scientists: A History of Science Told Through the Lives of Its Greatest Inventors. New York: Random House. pp. 558–569. ISBN 978-0812967883.
- Stone, Irwin (1982). The healing factor: "vitamin C" against disease. New York: Perigee Books. ISBN 978-0-399-50764-9.
- Dunitz, J. D. (1996). "Linus Carl Pauling. 28 February 1901–19 August 1994". Biographical Memoirs of Fellows of the Royal Society. 42 (9): 316–326. doi:10.1098/rsbm.1996.0020. PMID 11619334.
- "Linus Pauling's Childhood (1901–1910)". Special collections. Oregon State University Libraries. Retrieved April 25, 2013.
- Hager, p. 22.
- Mead and Hager, p. 8.
- Goertzel and Goertzel, p. 4.
- Goertzel and Goertzel, p. 5.
- Mead and Hager, p. 9.
- Goertzel and Goertzel, p. 17.
- Abrams, Irwin (1988). The Nobel Peace Prize and the laureates : an illustrated biographical history, 1901–1987 (2. print. ed.). Boston: G.K. Hall. ISBN 978-0816186099.
- Goertzel and Goertzel, p. 21.
- Goertzel and Goertzel, p. 22.
- Hager, p. 48.
- Bourgoin, Suzanne M.; Paula K. Byers (1998). Encyclopedia of World Biography. Thomson Gale. Vol. 12, p. 150. ISBN 978-0-7876-2221-3.
- Friedman, Ralph (September 6, 1962). "Nobel prize winner finally receives high school diploma". Index-Journal. Greenwood, SC. p. 13 – via Newspapers.com.
- Goertzel and Goertzel, p. 23.
- Goertzel and Goertzel, p. 24.
- Goertzel and Goertzel, p. 25.
- Goertzel and Goertzel, p. 26.
- Swanson, Stephen (October 3, 2000). "OSU fraternity to donate Pauling treasures to campus library". Oregon State University. Retrieved April 29, 2013.
- Goertzel and Goertzel, p. 29.
- "Pauling's Years as an Undergraduate at Oregon Agricultural College, Part 2 (1919–1922)". Special Collections and Archives Research Center. Oregon State University. Retrieved May 27, 2015.
He is also an assistant to Samuel H. Graf in a mechanics and materials course.
- Pauling, Linus (1995). Marinacci, Barbara (ed.). Linus Pauling: in his own words : selected writings, speeches, and interviews. New York: Simon & Schuster. p. 39. ISBN 9780684813875. Retrieved May 27, 2015.
Graf gave me a job correcting papers in the courses he taught, about statics and dynamics, bridge structure, strength of materials, and so on. I also helped him in the laboratory.
- Goertzel and Goertzel, p. 29, say he helped Graf to teach "an advanced mathematics course" which "required a grasp of mathematics and physics".
- Goertzel and Goertzel, p. 31.
- "Linus Pauling Biographical Timeline". Linus Pauling Institute. Retrieved November 10, 2011.
- Richard, Terry (May 3, 2013). "Ava Helen Pauling, wife of Linus Pauling, subject of biography by Corvallis author Mina Carson". The Oregonian. Retrieved June 2, 2015.
- "Commencement 1925 California Institute of Technology Pasadena" (PDF). Caltech Campus Publications. June 12, 1925. Retrieved March 29, 2013.
- Cohen, R.S.; Hilpinen, R.; Qiu, Ren-Zong (2011). Realism and anti-realism in the philosophy of science. Dordrecht: Springer. p. 161. ISBN 978-9048144938. Retrieved May 27, 2015.
- "About Linus Pauling". Pacific Northwest National Laboratory. Retrieved May 27, 2015.
- Sturchio, Jeffrey L. (April 6, 1987). Linus C. Pauling, Transcript of an Interview Conducted by Jeffrey L. Sturchio in Denver, Colorado on 6 April 1987 (PDF). Philadelphia, PA: Chemical Heritage Foundation.
- Pauling, Linus (1929). "The principles determining the structure of complex ionic crystals". J. Am. Chem. Soc. 51 (4): 1010–1026. doi:10.1021/ja01379a006.
- Pauling, Linus (1960). The nature of the chemical bond and the structure of molecules and crystals; an introduction to modern structural chemistry (3rd ed.). Ithaca (NY): Cornell University Press. pp. 543–562. ISBN 978-0-8014-0333-0.
- Hager, Tom (December 2004). "The Langmuir Prize". Oregon State University Libraries Special Collections. Retrieved February 29, 2008.
- Pauling, Linus (1932). "The nature of the chemical bond. III. The transition from one extreme bond type to another". Journal of the American Chemical Society. 54 (3): 988–1003. doi:10.1021/ja01342a022.
- Hager, Thomas (1995). Force of Nature: The Life of Linus Pauling. Simon & Schuster. ISBN 978-0-684-80909-0.
- Monk, Ray (2014). Robert Oppenheimer : a life inside the center (First Anchor Books ed.). Anchor. ISBN 978-0385722049.
- "Early Career at the California Institute of Technology (1927–1930)". Oregon State University Libraries Special Collections & Archives Research Center. Retrieved May 18, 2017.
- "A Lost Ally". Linus Pauling – The Nature of the Chemical Bond. Retrieved May 27, 2015.
- Hargittai, István; Hargittai, Magdolna (2000). In our own image : personal symmetry in discovery. New York, NY [u.a.]: Kluwer Academic/Plenum. ISBN 9780306460913. Retrieved May 27, 2015.
- Pauling, L. (1932). "The Nature of the Chemical Bond. IV. The Energy of Single Bonds and the Relative Electronegativity of Atoms". Journal of the American Chemical Society. 54 (9): 3570–3582. doi:10.1021/ja01348a011.
- "The Pauling Electronegativity Scale: Part 2, Inspired by Biology". The Pauling Blog. Oregon State University Libraries Special Collections & Archives Research Center. March 17, 2009. Retrieved March 17, 2009.
- "Pauling's Obituary". independent.co.uk. The Independent. August 21, 1994. Retrieved January 25, 2018.
- "Outline of the George Fischer Baker Lectureship, Cornell University". Linus Pauling, The nature of the chemical bond, A documentary history.
- "Pauling's Lecturer Tenure at Cornell". The Pauling Blog. Oregon State University Libraries Special Collections & Archives Research Center. July 30, 2014. Retrieved June 3, 2015.
- Pauling, Linus (1986). The nature of the chemical bond and the structure of molecules and crystals : an introduction to modern structural chemistry (3rd ed.). Ithaca, N.Y.: Cornell University Press. ISBN 9780801403330. Retrieved June 2, 2015.
- Watson, James D. (2001). A passion for DNA : genes, genomes, and society (2003 ed.). Oxford: Oxford University Press. ISBN 978-0198604280.
- "The nature of the chemical bond (citations and estimated counts)". Google Scholar. Retrieved May 27, 2015.
- Pauling, Linus (1928). "London's paper. General ideas on bonds". Oregon State University Libraries Special Collections. Retrieved June 2, 2015.
- Pauling, Linus (1930s). "Notes and Calculations re: Electronegativity and the Electronegativity Scale". Oregon State University Libraries Special Collections. Retrieved February 29, 2008.
- Pauling, Linus (January 6, 1934). "Benzene". Oregon State University Libraries Special Collections. Retrieved February 29, 2008.
- Pauling, Linus (July 29, 1946). "Resonance". Oregon State University Libraries Special Collections. Retrieved February 29, 2008.
- Pauling, Linus (1929). "The principles determining the structure of complex ionic crystals". J. Am. Chem. Soc. 51 (4): 1010–1026. doi:10.1021/ja01379a006.
- Kay, Lily E. (1996). The molecular vision of life : Caltech, the Rockefeller Foundation, and the rise of the new biology. New York [u.a.]: Oxford University Press. pp. 148–151. ISBN 978-0195111439. Retrieved May 27, 2015.
- Califano, Salvatore (2012). Pathways to modern chemical physics. Heidelberg [Germany]: Springer. p. 198. ISBN 978-3-642-28179-2. Retrieved May 27, 2015.
- Livio, Mario (2014). Brilliant blunders : from Darwin to Einstein : colossal mistakes by great scientists that changed our understanding of life and the universe. [S.l.]: Simon & Schuster. ISBN 9781439192375.
- Pauling, L; Corey, RB (1951). "Configurations of Polypeptide Chains With Favored Orientations Around Single Bonds: Two New Pleated Sheets". Proceedings of the National Academy of Sciences of the United States of America. 37 (11): 729–40. Bibcode:1951PNAS...37..729P. doi:10.1073/pnas.37.11.729. PMC 1063460. PMID 16578412.
- Goertzel and Goertzel, p. 95-100.
- Pauling, L; Corey, RB (February 1953). "A Proposed Structure For The Nucleic Acids". Proc Natl Acad Sci U S A. 39 (2): 84–97. Bibcode:1953PNAS...39...84P. doi:10.1073/pnas.39.2.84. PMC 1063734. PMID 16578429.
- "Linus Pauling's DNA Model". Archived from the original on February 4, 2012. Retrieved June 2, 2015.
- Metzler, David E. (2003). Biochemistry (2nd ed.). San Diego: Harcourt, Academic Pr. ISBN 9780124925410.
- Lewis, Julius M. Cruse, Robert E. (2010). Atlas of immunology (3rd ed.). Boca Raton, FL: CRC Press/Taylor & Francis. p. 21. ISBN 978-1439802687. Retrieved May 27, 2015.
- Tudge, Colin (1995). The engineer in the garden : genes and genetics : from the idea of heredity to the creation of life (1st American ed.). New York: Hill and Wang. ISBN 9780809042593. Retrieved May 27, 2015.
- Pauling, L.; Itano, H. A.; Singer, S. J.; Wells, I. C. (November 25, 1949). "Sickle Cell Anemia, a Molecular Disease". Science. 110 (2865): 543–548. Bibcode:1949Sci...110..543P. doi:10.1126/science.110.2865.543. PMID 15395398. Retrieved June 2, 2015.
- Strasser, Bruno J. (August 30, 2002). "Linus Pauling's "molecular diseases": Between history and memory" (PDF). American Journal of Medical Genetics. 115 (2): 83–93. CiteSeerX 10.1.1.613.5672. doi:10.1002/ajmg.10542. PMID 12400054. Retrieved May 27, 2015.
- "A Flamboyant Scientist's Legacy : Scholar: Linus C. Pauling's supporters and detractors join in calling the two-time Nobel winner one of the most significant figures of this century". Los Angeles Times. August 21, 1994. Retrieved June 1, 2015.
- Pauling, Linus (October 1951). "Molecular Medicine". Ava Helen and Linus Pauling Papers. Retrieved August 5, 2007.
- Pauling, Linus (1965). "The Close-Packed Spheron Model of atomic nuclei and its relation to the shell model". Proceedings of the National Academy of Sciences of the United States of America. 54 (4): 989–994. Bibcode:1965PNAS...54..989P. doi:10.1073/pnas.54.4.989. PMC 219778. PMID 16578621.
- Pauling, L (October 15, 1965). "The close-packed-spheron theory and nuclear fission". Science. 150 (3694): 297–305. Bibcode:1965Sci...150..297P. doi:10.1126/science.150.3694.297. PMID 17742357.
- Pauling, Linus (July 1966). "The close-packed-spheron theory of nuclear structure and the neutron excess for stable nuclei (Dedicated to the seventieth anniversary of Professor Horia Hulubei)". Revue Roumain de Physique. Retrieved August 5, 2007.
- Pauling, Linus (December 1967). "Magnetic-moment evidence for the polyspheron structure of the lighter atomic nuclei". Proceedings of the National Academy of Sciences. 58 (6): 2175–2178. Bibcode:1967PNAS...58.2175P. doi:10.1073/pnas.58.6.2175. PMC 223816. PMID 16591577. Retrieved August 5, 2007.
- Pauling, Linus (November 1969). "Orbiting clusters in atomic nuclei". Proceedings of the National Academy of Sciences of the United States of America. Proceedings of the National Academy of Sciences. 64 (3): 807–9. Bibcode:1969PNAS...64..807P. doi:10.1073/pnas.64.3.807. PMC 223305. PMID 16591799. Retrieved August 5, 2007.
- Pauling, Linus; Arthur B. Robinson (1975). "Rotating clusters in nuclei". Canadian Journal of Physics. Retrieved August 5, 2007.
- Pauling, Linus (February 1991). "Transition from one revolving cluster to two revolving clusters in the ground-state rotational bands of nuclei in the lanthanon region". Proc. Natl. Acad. Sci. 88 (3): 820–823. Bibcode:1991PNAS...88..820P. doi:10.1073/pnas.88.3.820. PMC 50905. PMID 11607150. Retrieved August 5, 2007.
- Pauling, Linus (November 15, 1969). "Orbiting clusters in atomic nuclei". Proceedings of the National Academy of Sciences. 64 (3): 807–809. Bibcode:1969PNAS...64..807P. doi:10.1073/pnas.64.3.807. PMC 223305. PMID 16591799.
- "Linus C. Pauling, Ph.D. Biography and Interview". www.achievement.org. American Academy of Achievement.
- "Hiroshima". Linus Pauling and the International Peace Movement. Special Collections & Archives Research Center, Oregon State University. Retrieved May 27, 2015.
- Kay, Lily E. (1996). The molecular vision of life : Caltech, the Rockefeller Foundation, and the rise of the new biology. New York: Oxford University Press. p. 179. ISBN 978-0195111439. Retrieved December 27, 2015.
- Arnold Thackray & Minor Myers, Jr. (2000). Arnold O. Beckman : one hundred years of excellence. foreword by James D. Watson. Philadelphia, Pa.: Chemical Heritage Foundation. ISBN 978-0-941901-23-9.
- "Beckman D2 Oxygen Analyzer". Wood Library-Museum of Anesthesiology. Retrieved May 28, 2015.
- "Blood and War: The Development of Oxypolygelatin, Part 1". The Pauling Blog. January 27, 2009. Retrieved May 28, 2015.
- Chadarevian, Soraya de (1998). Molecularizing biology and medicine new practices and alliances, 1910s–1970s. Amsterdam: Harwood Academic. p. 109. ISBN 978-9057022937. Retrieved May 28, 2015.
- "Presidential Medal for Merit". Linus Pauling Awards Honors and Medals. Retrieved May 28, 2015.
- "The Linus Pauling Papers: Biographical Information". United States National Library of Medicine. Retrieved February 11, 2008.
- Paulus, John Allen (November 5, 1995). "Pauling's Prizes". New York Times. Retrieved December 9, 2007.
- "ACS President: Linus Pauling (1901–1994)". ACS Chemistry for Life. Retrieved June 1, 2015.
- Part VI: The Manhattan District in Peacetime: The May-Johnson Bill, Atomic Archive, 1998, retrieved October 19, 2019
- Atomic Energy Commission, Atomic Heritage Foundation, November 18, 2016, retrieved October 19, 2019
- Roy Glauber & Priscilla McMillan on Oppenheimer – Atomic Energy Commission, Voices of the Manhattan Project, June 6, 2013, retrieved October 19, 2019
- The Independent Citizens Committee of the Arts, Sciences and Professions, Linus Pauling and the International Peace Movement, 2009, retrieved October 19, 2019
- Hager, Thomas (November 29, 2007). "Einstein". Oregon State University Libraries Special Collections. Retrieved December 13, 2007.
- "Linus Pauling". U.S. Stamp Gallery. Retrieved June 2, 2015.
[In] January of 1952, Pauling requested a passport to attend a meeting in England ... The passport was denied because granting it "would not be in the best interest of the United States." He applied again and wrote President Eisenhower, asking him to arrange the issuance of the passport since, "I am a loyal citizen of the United States. I have never been guilty of any unpatriotic or criminal act."
- Pauling, Linus (May 1952). "The Department of State and the Structure of Proteins". Oregon State University Libraries Special Collections. Retrieved December 13, 2007.
- Robert Paradowski (2011), Oregon State University, Special Collections p.18, Proteins, Passports, and the Prize (1950–1954), retrieved February 1, 2013
- Bulletin of the Atomic Scientists Vol. VIII, Nr. 7 (Okt. 1952) p. 254, Educational Foundation for Nuclear Science, Inc.
- Hager, Thomas (November 29, 2007). "Russell/Einstein". Oregon State University Libraries Special Collections. Retrieved December 13, 2007.
- Hermann, Armin (1979). The new physics : the route into the atomic age : in memory of Albert Einstein, Max von Laue, Otto Hahn, Lise Meitner. Bonn-Bad Godesberg: Inter Nationes. p. 130.
- "The Baby Tooth Survey". The Pauling Blog. Retrieved June 1, 2011.
- "The Nobel Peace Prize 1962 Linus Pauling: Nobel Lecture". Nobel Prize.org. Retrieved May 28, 2015.
- "Linus Pauling Receives the Nobel Peace Prize". The Pauling Blog. Retrieved December 10, 2013.
- Moore, Kelly (2008). Disrupting science : social movements, American scientists, and the politics of the military, 1945–1975. Princeton: Princeton University Press. p. 113. ISBN 978-0-691-11352-4. Retrieved May 28, 2015.
- Reiss, Louise Zibold (November 24, 1961). "Strontium-90 Absorption by Deciduous Teeth: Analysis of teeth provides a practicable method of monitoring strontium-90 uptake by human populations". Science. 134 (3491): 1669–1673. doi:10.1126/science.134.3491.1669. PMID 14491339.
- Hager, Thomas (November 29, 2007). "Strontium-90". Oregon State University Libraries Special Collections. Retrieved December 13, 2007.
- Hager, Thomas (November 29, 2007). "The Right to Petition". Oregon State University Libraries Special Collections. Retrieved December 13, 2007.
- McCormick, John (1991). Reclaiming paradise : the global environmental movement (1st Midland ed.). Bloomington: Indiana University Press. ISBN 9780253206602. Retrieved May 27, 2015.
- Allen, Garland E.; MacLeod, Roy M. (2001). Science, history and social activism : a tribute to Everett Mendelsohn. Dordrecht: Kluwer Academic. p. 302. ISBN 978-1402004957. Retrieved May 27, 2015.
- "Nobel Peace Prize Awarded to Pauling". Palo Alto Times. October 10, 1963. Retrieved May 27, 2015.
- Pauling, Linus (October 10, 1963). "Notes by Linus Pauling. October 10, 1963". Oregon State University Libraries Special Collections. Retrieved December 13, 2007.
- "Linus Pauling Biography". Linus Pauling Institute. May 9, 2014. Retrieved June 2, 2015.
Pauling said that his Nobel Peace Prize should really have gone to her, or at least been shared between them.
- "issued to Linus Pauling by the Internal Security Subcommittee of the United States Senate. June 20, 1960". Linus Pauling and the International Peace Movement. Retrieved May 28, 2015.
- Mason, Stephen F. (1997). "The Science and Humanism of Linus Pauling (1901–1994)". Chemical Society Reviews. 26: 29–39. doi:10.1039/cs9972600029. Archived from the original on May 15, 2009. Retrieved May 20, 2015.
- Kovac, Jeffrey (1999). "A weird insult from Norway: Linus Pauling as public intellectual". Soundings: An Interdisciplinary Journal. 82 (1/2): 91–106. JSTOR 41178914.
- "A Weird Insult From Norway". Life. Vol. 5 no. 17. October 25, 1963. p. 4.
- "The National Review Lawsuit". Paulingblog. January 30, 2013. Retrieved December 20, 2013.
- "A Tough Conclusion to the National Review Lawsuit". Paulingblog. Retrieved December 20, 2013.
- "Pauling v. NAT'L REVIEW, INC". Justia.com. Retrieved December 20, 2013.
- Saxon, Wolfgang (August 30, 1998). "C. Dickerman Williams, 97, Free-Speech Lawyer, Is Dead". The New York Times. Retrieved December 20, 2013.
- "Linus Pauling and the International Peace Movement: Vietnam". Oregon State University Libraries. 2010.
- "Lenin Peace Prize Recipients". Research History. May 16, 2011.
- "Founders". International League of Humanists for peace and tolerance. Archived from the original on June 11, 2015. Retrieved May 28, 2015.
- "The Dubrovnik-Philadelphia Statement /1974–1976/ (short version)". International League of Humanists. Archived from the original on September 24, 2015. Retrieved May 28, 2015.
- "History". International Academy of Science, Munich. Retrieved March 16, 2015.
- Mendelsohn, Everett (March–April 2000). "The Eugenic Temptation". Harvard Magazine.
- Special Collections & Archives Research Center, Oregon State University Libraries (2015). "Eugenics for Alleviating Human Suffering". It's in the Blood! A Documentary History of Linus Pauling, Hemoglobin and Sickle Cell Anemia. Retrieved May 30, 2020.
- Pauling, Linus (1987). How to Live Longer and Feel Better (1 ed.). New York: Avon Books. OL 18076125M.
- Peitzman, Steven J. (2007). Dropsy, dialysis, transplant: a short history of failing kidneys. Baltimore: Johns Hopkins University Press. pp. 72–8, 190. ISBN 978-0-8018-8734-5.
- Nicolle, Lorraine; Beirne, Ann Woodriff, eds. (2010). Biochemical imbalances in disease a practitioner's handbook. London: Singing Dragon. p. 27. ISBN 9780857010285.
- Pauling, Linus (April 1968). "Orthomolecular psychiatry. Varying the concentrations of substances normally present in the human body may control mental disease". Science. 160 (3825): 265–71. Bibcode:1968Sci...160..265P. doi:10.1126/science.160.3825.265. PMID 5641253. S2CID 20153555.
- Cassileth, Barrie R. (1998). The alternative medicine handbook: the complete reference guide to alternative and complementary therapies. New York: W.W. Norton. p. 67. ISBN 978-0-393-04566-6.
- "Vitamin Therapy, Megadose / Orthomolecular Therapy". BC Cancer Agency. February 2000. Archived from the original on February 2, 2007. Retrieved August 5, 2007.
- "PaulingTherapy.com – Reversing Heart Disease w/o Drugs is Possible". www.paulingtherapy.com.
- Cameron, Ewan. "Cancer Bibliography: Ewan Cameron, M.D. and Vitamin C Therapy". Doctoryourself.com. Retrieved August 5, 2007.
- Severo, Richard (August 21, 1994). "Linus C. Pauling Dies at 93; Chemist and Voice for Peace". The New York Times. Retrieved June 1, 2015.
- Cameron, E; Pauling, L (October 1976). "Supplemental ascorbate in the supportive treatment of cancer: Prolongation of survival times in terminal human cancer". Proceedings of the National Academy of Sciences. 73 (10): 3685–9. Bibcode:1976PNAS...73.3685C. doi:10.1073/pnas.73.10.3685. PMC 431183. PMID 1068480.
- Cameron, E; Pauling, L (September 1978). "Supplemental ascorbate in the supportive treatment of cancer: Reevaluation of prolongation of survival times in terminal human cancer". Proceedings of the National Academy of Sciences. 75 (9): 4538–42. Bibcode:1978PNAS...75.4538C. doi:10.1073/pnas.75.9.4538. PMC 336151. PMID 279931.
- DeWys, WD (1982). "How to evaluate a new treatment for cancer". Your Patient and Cancer. 2 (5): 31–36.
- Creagan, ET; Moertel, CG; O'Fallon, JR (September 1979). "Failure of high-dose vitamin C (ascorbic acid) therapy to benefit patients with advanced cancer. A controlled trial". The New England Journal of Medicine. 301 (13): 687–90. doi:10.1056/NEJM197909273011303. PMID 384241.
- Moertel, CG; Fleming, TR; Creagan, ET; Rubin, J; O'Connell, MJ; Ames, MM (January 1985). "High-dose vitamin C versus placebo in the treatment of patients with advanced cancer who have had no prior chemotherapy. A randomized double-blind comparison". The New England Journal of Medicine. 312 (3): 137–41. doi:10.1056/NEJM198501173120301. PMID 3880867.
- Tschetter, L; et al. (1983). "A community-based study of vitamin C (ascorbic acid) in patients with advanced cancer". Proceedings of the American Society of Clinical Oncology. 2: 92.
- Chen, Q; Espey, M. G.; Sun, A. Y.; Lee, J.-H.; Krishna, M. C.; Shacter, E.; Choyke, P. L.; Pooput, C.; Kirk, K. L.; Buettner, G. R.; Levine, M.; et al. (2007). "Ascorbate in pharmacologic concentrations selectively generates ascorbate radical and hydrogen peroxide in extracellular fluid in vivo". Proceedings of the National Academy of Sciences. 104 (21): 8749–54. Bibcode:2007PNAS..104.8749C. doi:10.1073/pnas.0702854104. PMC 1885574. PMID 17502596.
- Goertzel, Ted (1996). "Analyzing Pauling's Personality: A Three Generational, Three Decade Project". Special Collections, Oregon State University Libraries. Archived from the original on October 14, 2007. Retrieved August 5, 2007.
- Pinch, Trevor; Collins, Harry M. (2005). "Alternative Medicine: The Cases of Vitamin C and Cancer". Dr. Golem: how to think about medicine. Chicago: University of Chicago Press. pp. 89–111. ISBN 978-0-226-11366-1.
- Levine, M; et al. (2006). "Intravenously administered vitamin C as cancer therapy: three cases". CMAJ. 174 (7): 937–942. doi:10.1503/cmaj.050346. PMC 1405876. PMID 16567755.
- Pauling, Linus (1986). How to Live Longer and Feel Better. New York: W.H. Freeman and Company. pp. 173–175. ISBN 978-0-7167-1781-2.
- Pauling, L (November 1978). Ralph Pelligra (ed.). "Orthomolecular enhancement of human development" (PDF). Human Neurological Development: 47–51.
- Saul, Andrew W.; Dr. Abram Hoffer. "Abram Hoffer, M.D., PhD 50 Years of Megavitamin Research, Practice and Publication". Doctoryourself.com. Retrieved August 5, 2007.
- Ohno, S; Ohno, Y; Suzuki, N; Soma, G; Inoue, M (2009). "High-dose vitamin C (ascorbic acid) therapy in the treatment of patients with advanced cancer". Anticancer Research. 29 (3): 809–15. PMID 19414313.
- "The Linus Pauling Papers: Biographical Information". United States National Library of Medicine. n.d. Retrieved November 10, 2011.
- "Linus Pauling Biography". Linus Pauling Institute. Retrieved November 10, 2011.
- "Oral history interview with Linus Carl Pauling, 1964 March 27". American Institute of Physics. Retrieved May 27, 2015.
- "Linus Pauling". Dictionary of Unitarian & Universalist Biography. Retrieved May 27, 2015.
- Pauling, Linus; Ikeda, Daisaku (1992). A Lifelong Quest for Peace: A Dialogue. Jones & Bartlett. p. 22. ISBN 978-0-86720-277-9.
...I [Pauling] am not, however, militant in my atheism. The great English theoretical physicist Paul Dirac is a militant atheist. I suppose he is interested in arguing about the existence of God. I am not. It was once quipped that there is no God and Dirac is his prophet.
- "Dr. Pauling Rescued, On a Sea Cliff 24 Hrs" (clipping). scarc.library.oregonstate.edu. Special Collections & Archives Research Center, Oregon State University Libraries: New York Herald Tribune. February 1, 1960. Retrieved April 22, 2018.
- Offit, Paul (July 19, 2013). "The Vitamin Myth: Why We Think We Need Supplements". The Atlantic. Retrieved July 19, 2013.
- Goertzel and Goertzel, p. 247.
- "The Centennial: Who's Buried in Linus Pauling's Grave?" (PDF). Retrieved December 26, 2012.
- "Linus Pauling". California Museum. Retrieved June 1, 2015.
- "Linus Pauling – Biographical". Nobelprize.org. Nobel Media AB 2014. Retrieved October 6, 2016.
- Hamilton, Neil A. (2002). American social leaders and activists. New York: Facts On File. ISBN 978-0816045358. Retrieved June 1, 2015.
- Hoffmann, Roald; Shaik, Sason; Hiberty, Philippe C. (2003). "A Conversation on VB vs MO Theory: A Never-Ending Rivalry?". Acc Chem Res. 36 (10): 750–6. doi:10.1021/ar030162a. PMID 14567708.
- "Pauling Honored by Scientists at Caltech Event". Los Angeles Times. United Press International. March 1, 1986. Retrieved July 22, 2012.
- "Citations for Chemical Breakthrough Awards 2017 Awardees". Division of the History of Chemistry. Retrieved March 12, 2018.
- Pauling, L.; Corey, R. B.; Branson, H. R. (1951). "The structure of proteins: Two hydrogen-bonded helical configurations of the polypeptide chain". Proceedings of the National Academy of Sciences. 37 (4): 205–11. Bibcode:1951PNAS...37..205P. doi:10.1073/pnas.37.4.205. PMC 1063337. PMID 14816373.
- "Linus Pauling Science Center | Department of Chemistry | Oregon State University". chemistry.oregonstate.edu. Retrieved November 10, 2016.
- "Four Legends of American Science Now on U.S. Postage Stamps" (PDF). United States Postal Service Postal News, Release No. 08-23. March 6, 2008.
- "OSU Celebrates Linus Pauling and Release of New U.S. Postal Service Stamp". Oregon State University – University Events. Retrieved February 25, 2015.
- "Governor & First Lady Participate in 2008 CA Hall of Fame Induction Ceremony". CA.gov. Archived from the original on June 2, 2015. Retrieved June 1, 2015.
- "Linus Pauling Research Notebooks Online". Natural Science. Archived from the original on September 5, 2015. Retrieved June 1, 2015.
- "Linus Pauling Institute". Lpi.oregonstate.edu. Retrieved June 25, 2013.
- Cole, Gail (October 14, 2011). "Linus Pauling Science Center opens at OSU". Corvallis Gazette-Times. Retrieved June 2, 2015.
- "Linus Pauling Science Center – A Moment to Celebrate". Oregon State University Foundation. Retrieved June 2, 2015.
- Zewail, Ahmed (1992). The Chemical Bond Structure and Dynamics. Burlington: Elsevier Science. ISBN 9780080926698. Retrieved June 1, 2015.
- Baum, Rudy (December 11, 1989). "Caltech launches Linus Pauling lecture series". Chemical & Engineering News. 67 (50): 18–19. doi:10.1021/cen-v067n050.p018a.
- Johnson, Greg (March 20, 1996). "Pauling Road Address Fits New Vitamin Factory to a 'C'". Los Angeles Times. Retrieved June 2, 2015.
- Gottlieb, Jeff (August 19, 2001). "A New-View University". Los Angeles Times. Retrieved June 1, 2015.
- Woodward, Raju (February 29, 2012). "A son's tribute by Linus Pauling Jr". Corvallis Gazette-Times. Retrieved June 1, 2015.
- "Scientist cites Condon years as influential". Register-Guard, Eugene, Oregon. October 19, 1988. Retrieved June 1, 2015.
- Heberlein, L. A. (2002). The Rough guide to internet radio. London: Rough Guides. ISBN 978-1858289618. Retrieved June 1, 2015.
- Schmadel, Lutz D. (2012). Dictionary of minor planet names (6th ed.). Berlin: Springer. ISBN 9783642297182. Retrieved June 1, 2015.
- Moody, Glyn (2002). Rebel Code: Linux and the Open Source Revolution. Perseus Books Group. p. 336. ISBN 978-0-7382-0670-7.
- Agre, Peter (December 10, 2013). "Fifty years ago: Linus Pauling and the belated Nobel Peace Prize". Science & Diplomacy. 2 (4).
- Center for Oral History. "Linus C. Pauling". Science History Institute.
- "Linus Pauling: Awards, Honors and Medals". Special Collections. Oregon State University Libraries. Retrieved April 25, 2013.
- "ACS Award in Pure Chemistry". American Chemical Society. Retrieved January 18, 2014.
- "Alpha Chi Sigma Fraternity, Certificate of Membership". Special Collections & Archives Research Center. Oregon State University Libraries. Retrieved May 27, 2015.
- Pauling's awards and medals (includes image of Fermat medal).
- "Gandhi Peace Award". Promoting Enduring Peace. Retrieved April 26, 2013.
- "Gold Medal Honorees". National Institute of Social Sciences.
- "NAS Award in Chemical Sciences". National Academy of Sciences. Retrieved June 2, 2015.
- "Golden Plate Awardees of the American Academy of Achievement". www.achievement.org. American Academy of Achievement.
- "OSU Celebrates Linus Pauling and Release of New U.S. Postal Service Stamp". Events. Oregon State University. Retrieved April 25, 2013.
Sources
- Goertzel, Ted; Goertzel, Ben (1995). Linus Pauling: A Life in Science and Politics. Basic Books. ISBN 978-0-465-00672-4. online
- Hager, Thomas (1995). Force of Nature: The Life of Linus Pauling. Simon & Schuster. ISBN 978-0-684-80909-0. online
- — (1998). Linus Pauling and the Chemistry of Life. Oxford University Press. ISBN 978-0-19-513972-3. online
- Marinacci, Barbara; Krishnamurthy, Ramesh (1998). Linus Pauling on Peace. Rising Star Press. ISBN 978-0-933670-03-7.
- Mead, Clifford; Hager, Thomas, eds. (2001). Linus Pauling: Scientist and Peacemaker. Oregon State University Press. ISBN 978-0-87071-489-4.
- Serafini, Anthony (1989). Linus Pauling: A Man and His Science. Paragon House. ISBN 978-1-55778-440-7. online
Further reading
- Coffey, Patrick (2008). Cathedrals of Science: The Personalities and Rivalries That Made Modern Chemistry. Oxford University Press. ISBN 978-0-19-532134-0.
- Davenport, Derek A. (1996). "The Many Lives of Linus Pauling: A Review of Reviews". Journal of Chemical Education. 73 (9): A210. Bibcode:1996JChEd..73A.210D. doi:10.1021/ed073pA210.
- Gormley, Melinda. "The first ‘molecular disease’: a story of Linus Pauling, the intellectual patron." Endeavour 31.2 (2007): 71-77 online.
- Mead, Clifford. Linus Pauling: Scientist and Peacemaker (2008)
- Nakamura, Jeanne, and Mihaly Csikszentmihalyi. "Catalytic creativity: The case of Linus Pauling." American Psychologist 56.4 (2001): 337+.
- Strasser, Bruno J. "A world in one dimension: Linus Pauling, Francis Crick and the central dogma of molecular biology." History and philosophy of the life sciences (2006): 491–512 online.
- Strasser, Bruno J. "Linus Pauling's “molecular diseases”: Between history and memory." American journal of medical genetics 115.2 (2002): 83–93 online.
- White, Florence Meiman. Linus Pauling Scientist and Crusader (1980) online
- Zannos, Susan. Linus Pauling and the chemical bond (2004), 48pp online, for secondary schools
Primary sources
- Hargittai, István (2000). Hargittai, Magdolna (ed.). Candid science: conversations with famous chemists (Reprinted ed.). London: Imperial College Press. ISBN 978-1860941511.
- Marinacci, Barbara, ed. (1995). Linus Pauling: In His Own Words; Selected Writings, Speeches, and Interviews. Introduction by Linus Pauling. New York: Simon & Schuster. ISBN 978-0684813875. online
- Pauling, Linus. Selected Scientific Papers Vol II online
- Sturchio, Jeffrey L. (April 6, 1987). Linus C. Pauling, Transcript of an Interview Conducted by Jeffrey L. Sturchio in Denver, Colorado on 6 April 1987 (PDF). Philadelphia, PA: Chemical Heritage Foundation.
External links
| Wikiquote has quotations related to: Linus Pauling |
| Wikimedia Commons has media related to Linus C. Pauling. |
- Linus Pauling Online a Pauling portal created by Oregon State University Libraries
- Crick, Francis, "The Impact of Linus Pauling on Molecular Biology" (transcribed from video at the 1995 Oregon State University symposium)
- The Ava Helen and Linus Pauling Papers at the Oregon State University Libraries
- The Pauling Catalogue
- Center for Oral History. "Linus C. Pauling". Science History Institute.
- Sturchio, Jeffrey L. (April 6, 1987). Linus C. Pauling, Transcript of an Interview Conducted by Jeffrey L. Sturchio in Denver, Colorado on 6 April 1987 (PDF). Philadelphia, PA: Chemical Heritage Foundation.
- The Pauling Blog
- Linus Pauling (1901–1994)
- Berkeley Conversations With History interview
- Linus Pauling Centenary Exhibit
- Linus Pauling from The Dictionary of Unitarian and Universalist Biography
- "It's in the Blood! A Documentary History of Linus Pauling, Hemoglobin and Sickle Cell Anemia – Special Collections & Archives Research Center – Oregon State University". Oregon State University Library. Retrieved February 25, 2015.
- The Linus Pauling Institute at Oregon State University
- Publications of Pauling
- The Linus Pauling Papers – Profiles in Science, National Library of Medicine
- Linus Pauling Documentary produced by Oregon Public Broadcasting
- Oral history interview with Linus C. Pauling from Science History Institute Digital Collections
| Awards and achievements | ||
|---|---|---|
| Preceded by Hermann Staudinger |
Laureate of the Nobel Prize in Chemistry 1954 |
Succeeded by Vincent du Vigneaud |
| Preceded by Dag Hammarskjöld |
Laureate of the Nobel Peace Prize 1962 |
Succeeded by International Committee of the Red Cross, League of Red Cross Societies |